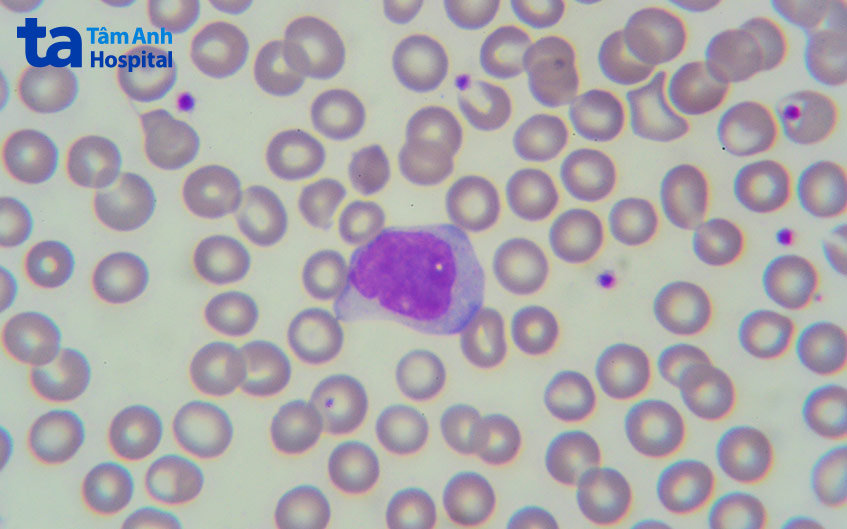

U sao bào độ 2 có thể xâm lấn và tái phát sau phẫu thuật. Người bệnh cần tuân theo phác đồ điều trị để tránh nguy cơ tử vong. Khối u sao bào độ 2 phát sinh từ tế bào hình sao, xảy ra phổ biến hơn so với u sao bào độ 1. Tuy nhiên, khác với u sao bào độ 1 chủ yếu xuất hiện ở trẻ em và thanh thiếu niên, u sao bào lan tỏa độ 2 thường xuất hiện ở người lớn.

U sao bào độ 2 (hay u sao bào lan tỏa độ 2) là một loại u thần kinh đệm lành tính nhưng có khả năng xâm lấn. Khối u sao bào độ 2 thường phát triển khá chậm và không có ranh giới rõ ràng. Tế bào của khối u có xu hướng xâm lấn, lan tỏa vào các mô lành xung quanh. Kết cấu khối u thường có các vi nang và chất nhầy.
U sao bào độ 2 chủ yếu hình thành trong não, được phát hiện nhiều hơn tại bán cầu não. Tuy nhiên, tại các vị trí khác của hệ thần kinh trung ương như hạch nền, thân não, tiểu não, tủy sống… đều có khả năng xuất hiện khối u sao bào lan tỏa độ 2. (1)

U não sao bào lan tỏa độ 2 chiếm khoảng 2 – 5% trên tổng số trường hợp u não nguyên phát ở người trưởng thành được ghi nhận và chiếm khoảng 10 – 15% các trường hợp mắc u tế bào hình sao. U sao bào lan tỏa độ 2 thường tái phát sau một khoảng thời gian điều trị, một số trường hợp tiến triển thành u ác tính.
Triệu chứng u sao bào lan tỏa độ 2 xuất hiện như thế nào còn tùy thuộc vào vị trí và kích thước của khối u. Tuy nhiên, hầu hết các khối u sao bào độ 2 nằm trong não bộ và gây ra hội chứng tăng áp lực nội sọ với những triệu chứng điển hình như đau đầu, chóng mặt, buồn nôn và nôn vọt vào buổi sáng… (2)
Trường hợp tăng áp lực nội sọ mức độ nặng còn có các biểu hiện như rối loạn hô hấp, mạch chậm, trầm cảm, rối loạn lo âu, tri giác chậm chạp, mất kiểm soát hành vi tiểu tiện và đại tiện, ngất xỉu, hôn mê…

Ngoài ra, u não sao bào lan tỏa độ 2 còn gây ra một số triệu chứng điển hình tùy vị trí khối u xuất hiện tại các vùng chức năng của não như:
Không chỉ xuất hiện ở não, u sao bào độ 2 còn có thể hình thành tại tủy sống. Khi đó, người bệnh thường gặp các triệu chứng như đau lưng/vùng cổ, yếu và liệt tay, chân, đi đứng khó khăn…
Nguyên nhân gây u não sao bào lan tỏa độ 2 đến nay vẫn chưa được xác định chính thức. Tuy nhiên, đột biến gen và rối loạn di truyền hiếm gặp có thể dẫn đến sự hình thành khối u sao bào độ 2, điển hình như:
U sao bào độ 2 xuất hiện phổ biến ở đối tượng người trưởng thành, trong độ tuổi từ 20 – 45 tuổi. Bệnh cũng có thể xuất hiện ở thanh thiếu niên (số ít). Nam giới thường có khả năng mắc u sao bào lan tỏa độ 2 cao hơn nữ giới.
>> Xem thêm: U sao bào độ 1: Triệu chứng, nguyên nhân, chẩn đoán và điều trị
U não sao bào lan tỏa độ 2 là dạng khối u khó loại bỏ hoàn toàn và có nguy cơ tái phát cao. Nếu không được phát hiện và điều trị kịp thời, u sao bào độ 2 có thể tiến triển thành u sao bào độ 3 hoặc 4, lúc này về mặt tiên lượng sẽ xấu hơn rất nhiều và khả năng điều trị thành công sẽ giảm xuống nhiều.
Ở một số trường hợp, u sao bào lan tỏa độ 2 còn gây ra sự nhầm lẫn trong chẩn đoán và lạc lối điều trị, khiến bệnh diễn biến nghiêm trọng hơn.
Ngoài ra, tùy vào vị trí, kích thước và biến chứng của khối u, người bệnh có thể đối mặt với những nguy cơ khác nhau như: mù lòa, khó thở, rối loạn nhịp tim, rối loạn giấc ngủ, suy giảm sức cơ, yếu liệt chi thể, mất vận ngôn… thậm chí dẫn đến tử vong.
Rất khó để khẳng định người bệnh u sao bào độ 2 có thể sống được bao lâu. Điều này còn tùy thuộc vào nhiều yếu tố như tuổi tác, các bệnh nền khác, cơ địa của từng người bệnh, vị trí và kích thước khối u, loại biến chứng người bệnh gặp phải, thời điểm phát hiện khối u, phương pháp điều trị, mức độ loại bỏ khối u khi tiến hành phẫu thuật, tinh thần của người bệnh…
Mốc thời gian trung bình mà bạn có thể tham khảo là khoảng 5 năm. Riêng với những trường hợp u não sao bào lan tỏa độ 2 tái phát hoặc di căn đến các cơ quan khác, khó điều trị thì tiên lượng tỷ lệ người bệnh tử vong trong khoảng thời gian ngắn là rất cao, trung bình rơi vào khoảng từ 6 – 12 tháng.
Qua thăm khám lâm sàng, nếu phát hiện các triệu chứng của khối u sao bào độ 2 (hay u não sao bào lan tỏa độ 2), bác sĩ có thể chỉ định cho người bệnh thực hiện một số xét nghiệm, kỹ thuật chẩn đoán hình ảnh như:

Có nhiều cách điều trị u sao bào lan tỏa độ 2 hay u tế bào hình sao độ 2. Dưới đây là một số phương pháp điều trị phổ biến:
Phẫu thuật là phương pháp điều trị được sử dụng phổ biến hơn cả để điều trị bệnh u sao bào lan tỏa độ 2. Các bác sĩ phẫu thuật thần kinh luôn mong muốn loại bỏ hoàn toàn khối u.
Tuy nhiên, loại u này có tính xâm lấn, lan tỏa vào các mô lành xung quanh nên rất khó để bóc tách và loại bỏ được hết. Nếu chỉ trông chờ vào kết quả phẫu thuật thì hiệu quả điều trị không cao và có nguy cơ cao tái phát trở lại. Trong nhiều trường hợp, bác sĩ có thể kết hợp phương pháp hóa trị hoặc xạ trị để giải quyết dứt điểm phần còn lại của khối u sau quá trình phẫu thuật.
Bệnh viện Đa khoa Tâm Anh triển khai hệ thống robot Modus V Synaptive ứng dụng trí tuệ nhân tạo (Al) để phẫu thuật điều trị các bệnh lý thần kinh – sọ não – cột sống, trong đó có u sao bào độ 2.
Robot mổ não mang đến nhiều tính năng ưu việt như: Hỗ trợ bác sĩ nhìn thấy rõ vị trí tổn thương, các bó sợi thần kinh, cấu trúc não xung quanh trên cùng một hình ảnh 3D cả trước, trong và sau mổ; cho phép tiến hành cuộc mổ mô phỏng, giúp bác sĩ chủ động chọn vị trí mở hộp sọ và đường mổ phù hợp.
Đồng thời hạn chế tối đa mọi yếu tố rủi ro; tích hợp hệ thống dẫn đường, kịp thời cảnh báo bác sĩ khi đường mổ hoặc thao tác trên dụng cụ mổ có sai lệch so với cuộc mổ mô phỏng; hỗ trợ bác sĩ thực hiện các thao tác với độ chính xác rất cao, loại bỏ u tối đa, tránh gặp biến chứng… (4)
Với phương pháp này, bác sĩ có thể chỉ định cho người bệnh sử dụng một số loại thuốc là hóa chất mạnh để tiêu diệt các tế bào của khối u sao bào độ 2 lan tỏa. Các loại thuốc này có thể ở dạng viên uống, dịch truyền qua tĩnh mạch hoặc những tấm mỏng được đặt vào vị trí bốc tách khối u trong quá trình phẫu thuật…
Tuy nhiên, hầu hết các loại thuốc hóa trị đều gây ra tác dụng phụ. Vì hóa chất không chỉ tiêu diệt các tế bào của khối u mà còn ảnh hưởng đến những tế bào lành, khiến cho sức khỏe người bệnh bị suy giảm ở một mức độ nhất định. Để hạn chế tác dụng phụ khi tiến hành hóa trị, người bệnh cần thực hiện theo đúng chỉ định của bác sĩ.
Xạ trị sử dụng chùm tia bức xạ có kiểm soát để đốt khối u, tiêu diệt các tế bào của u sao bào lan tỏa độ 2. Hiện nay có nhiều kỹ thuật xạ trị khác nhau như xạ trị thường quy, xạ trị dưới hướng dẫn hình ảnh, xạ trị quay điều biến thể tích, xạ phẫu, xạ trị hạt nặng…
Tuy nhiên, xạ trị thường hiếm khi được sử dụng cho đối tượng người bệnh là trẻ em và thanh thiếu niên. Vì sau nhiều năm điều trị có nguy cơ hình thành các khối u khác, hoặc gây biến đổi gen cho thế hệ sau.
Phương pháp này thường không thể điều trị triệt để u sao bào lan tỏa độ 2. Tuy nhiên, u sao bào lan tỏa độ 2 có nguy cơ tái phát cao nên sau khi điều trị bằng các phương pháp phẫu thuật, xạ trị hoặc hóa trị người bệnh có thể được chỉ định theo dõi và chữa trị triệu chứng.
Theo dõi, điều trị triệu chứng còn áp dụng cho các trường hợp người bệnh có sức khỏe yếu hoặc chưa sẵn sàng thực hiện những phương pháp chữa trị khác. Trong thời gian này, bác sĩ có thể chỉ định cho người bệnh dùng thuốc điều trị các triệu chứng do khối u gây ra, giảm đau và hỗ trợ người bệnh chung sống với bệnh cảnh.
Đặc biệt là tiến hành tái khám định kỳ, kết hợp thực hiện các xét nghiệm, kỹ thuật chẩn đoán hình ảnh cần thiết để theo dõi tiến triển của khối u sao bào lan tỏa độ 2. Khi khối u diễn tiến bất lợi hoặc người bệnh có điều kiện thích hợp, bác sĩ có thể chỉ định phương pháp khác nhằm nâng cao hiệu quả điều trị.
U sao bào độ 2 là loại u có tính xâm lấn, lan tỏa sang các mô lành xung quanh và có nguy cơ tái phát cao. Do vậy, rất khó để điều trị khỏi bệnh hoàn toàn nếu chỉ áp dụng riêng lẻ một phương pháp chữa trị. Trên thực tế, các bác sĩ thường chỉ định kết hợp nhiều phương pháp nêu trên để nâng cao hiệu quả điều trị cho người bệnh u sao bào lan tỏa độ 2.
Để đặt lịch thăm khám, tư vấn các vấn đề về sức khỏe tại Hệ thống Bệnh viện Đa khoa Tâm Anh, Quý khách vui lòng liên hệ:
HỆ THỐNG BỆNH VIỆN ĐA KHOA TÂM ANH
U sao bào độ 2 là bệnh lý nguy hiểm, có thể gây nhiều biến chứng nghiêm trọng, thậm chí gây tử vong. Do đó, ngay khi có dấu hiệu nghi ngờ bị u sao bào độ 2, người bệnh cần nhanh chóng đến cơ sở y tế uy tín thăm khám, chữa trị.